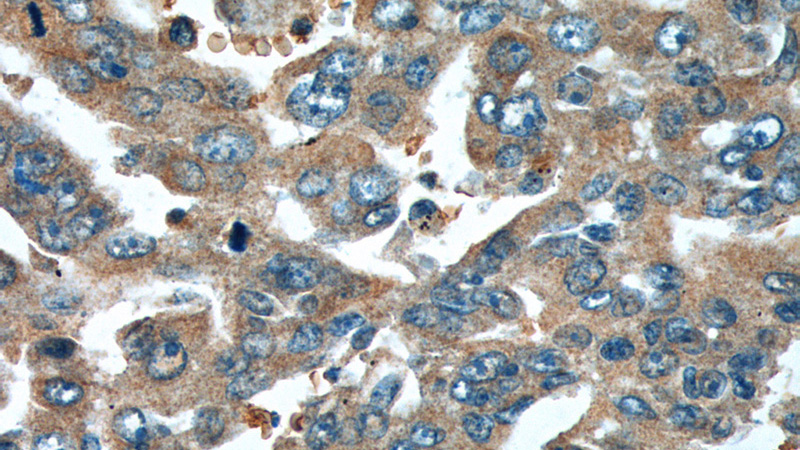
Immunohistochemistry of paraffin-embedded human lung cancer tissue slide using Catalog No:114923(RRM1 Antibody) at dilution of 1:200 (under 40x lens).

-
Product Name
RRM1 antibody
- Documents
-
Description
RRM1 Rabbit Polyclonal antibody. Positive WB detected in HeLa cells, A549, A549 cells, BxPC-3 cells, K-562 cells, rat skeletal muscle tissue. Positive IP detected in K-562 cells. Positive FC detected in HeLa cells. Positive IHC detected in human lung cancer tissue. Positive IF detected in Hela cells, HepG2 cells, MCF-7 cells. Observed molecular weight by Western-blot: 90 kDa
-
Tested applications
ELISA, IP, WB, IF, FC, IHC
-
Species reactivity
Human,Mouse,Rat, Monkey; other species not tested.
-
Alternative names
ribonucleotide reductase M1 antibody; RIR1 antibody; RR1 antibody; RRM1 antibody
-
Isotype
Rabbit IgG
-
Preparation
This antibody was obtained by immunization of RRM1 recombinant protein (Accession Number: NM_001033). Purification method: Antigen affinity purified.
-
Clonality
Polyclonal
-
Formulation
PBS with 0.1% sodium azide and 50% glycerol pH 7.3.
-
Storage instructions
Store at -20℃. DO NOT ALIQUOT
-
Applications
Recommended Dilution:
WB: 1:1000-1:10000
IP: 1:200-1:2000
IHC: 1:20-1:200
IF: 1:20-1:200
-
Validations

HeLa cells were subjected to SDS PAGE followed by western blot with Catalog No:114923(RRM1 antibody) at dilution of 1:2000

A549 cells (shcontrol and shRNA of RRM1) were subjected to SDS PAGE followed by western blot with Catalog No:114923 (RRM1 antibody) at dilution of 1:2000. (Data provided by Angran Biotech (www.miRNAlab.com)).

IP Result of anti-RRM1 (IP:Catalog No:114923, 5ug; Detection:Catalog No:114923 1:800) with K-562 cells lysate 8000ug.

Immunofluorescent analysis of Hela cells, using RRM1 antibody Catalog No:114923 at 1:50 dilution and Rhodamine-labeled goat anti-rabbit IgG (red). Blue pseudocolor = DAPI (fluorescent DNA dye).

Immunohistochemistry of paraffin-embedded human lung cancer tissue slide using Catalog No:114923(RRM1 Antibody) at dilution of 1:200 (under 10x lens).
Immunohistochemistry of paraffin-embedded human lung cancer tissue slide using Catalog No:114923(RRM1 Antibody) at dilution of 1:200 (under 40x lens).

1X10^6 HeLa cells were stained with .2ug RRM1 antibody (Catalog No:114923, red) and control antibody (blue). Fixed with 4% PFA blocked with 3% BSA (30 min). Alexa Fluor 488-congugated AffiniPure Goat Anti-Rabbit IgG(H+L) with dilution 1:1000.
-
Background
Ribonucleoside-diphosphate reductase functions as a heterodimer of a large and a small subunits in deoxyribonucleotide synthesis. RRM1 constitutes to the large subunit (R1) of ribonucleotide reductase, and it can either form heterodimer with small subunit RRM or RRM2B(PMID:16376858). RRM1 provides the precursors necessary for DNA synthesis. RRM1 can not be detected in quiescent cells, while its mRNA and protein are present throughout the cell cycle in cycling cells(PMID:8188248). Researches showed that RRM1 is involved in carcinogenesis, tumor progression, and the resistance of non-small-cell lung cancer (NSCLC) to treatment. Low level expression of RRM1 in NSCLC is associated with poor survival(PMID:17314339).
-
References
- Kerr M, Scott HE, Groselj B. Deoxycytidine kinase expression underpins response to gemcitabine in bladder cancer. Clinical cancer research : an official journal of the American Association for Cancer Research. 20(21):5435-45. 2014.
- Wang Q, Liu X, Zhou J. Ribonucleotide reductase large subunit M1 predicts poor survival due to modulation of proliferative and invasive ability of gastric cancer. PloS one. 8(7):e70191. 2013.
- Dong X, Hao Y, Wei Y, Yin Q, Du J, Zhao X. Response to first-line chemotherapy in patients with non-small cell lung cancer according to RRM1 expression. PloS one. 9(3):e92320. 2014.
- Lundy SD, Murphy SA, Dupras SK. Cell-based delivery of dATP via gap junctions enhances cardiac contractility. Journal of molecular and cellular cardiology. 72:350-9. 2014.
- Okimoto T, Tsubata Y, Sutani A. Immunohistochemical comparison of biomarker expression in biopsy and surgical specimens of non-small cell lung cancer. Anticancer research. 34(6):2755-61. 2014.
- Millis SZ, Bryant D, Basu G. Molecular profiling of infiltrating urothelial carcinoma of bladder and nonbladder origin. Clinical genitourinary cancer. 13(1):e37-49. 2015.
- Jordheim LP, Sève P, Trédan O, Dumontet C. The ribonucleotide reductase large subunit (RRM1) as a predictive factor in patients with cancer. The Lancet. Oncology. 12(7):693-702. 2011.
- Zheng Z, Chen T, Li X, Haura E, Sharma A, Bepler G. DNA synthesis and repair genes RRM1 and ERCC1 in lung cancer. The New England journal of medicine. 356(8):800-8. 2007.
Related Products / Services
Please note: All products are "FOR RESEARCH USE ONLY AND ARE NOT INTENDED FOR DIAGNOSTIC OR THERAPEUTIC USE"
